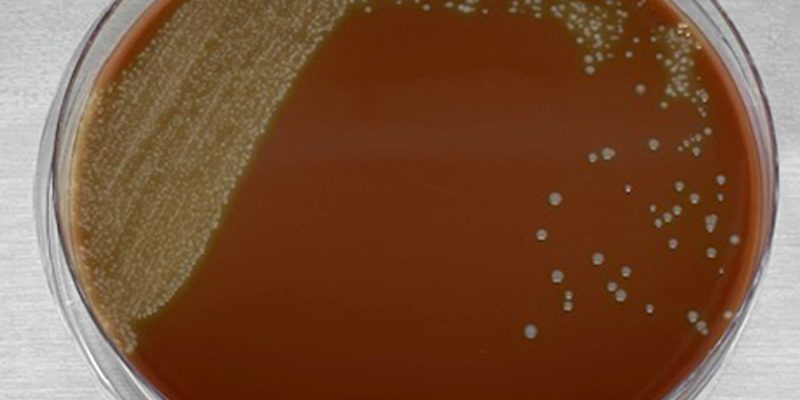
S-suis-Ag-Xoco

Streptococcus suis.
Os presentamos un nuevo caso.
El cliente nos ha enviado cráneos de lechones de transición con sintomatología nerviosa (postración, pedaleo) y nos pide descartar la meningitis causada por Streptococcus suis.
El S. suis se puede encontrar en animales con infecciones subclínicas, siendo portadores de la bacteria en la cavidad nasal, tonsilas, vagina y tracto digestivo. Hay que tener en cuenta que no todas las cepas de S. suis son virulentas, pero puede producir infecciones con sintomatología clínica, provocando cuadros de meningitis, artritis, endocarditis, neumonías y septicemias.
En este caso, tomamos muestras de las meninges mediante hisopos e inmediatamente procedemos a la siembra en Agar sangre y Agar chocolate.
Después de 24 horas de incubación a 37ºC, se ha observado mayoritariamente un crecimiento de colonias blanquinosas pequeñas con un halo de hemólisis en el Agar sangre y amarillentas en Agar chocolate.
Hemos procedido al aislamiento e identificación de estas colonias mediante MALDI-TOF y luego hemos realizado un antibiograma para determinar la pauta de mediación para tratar a los #animales.
Desde Zenit ofrecemos a cada nuevo caso, una solución a medida.
Zenit, your global sight